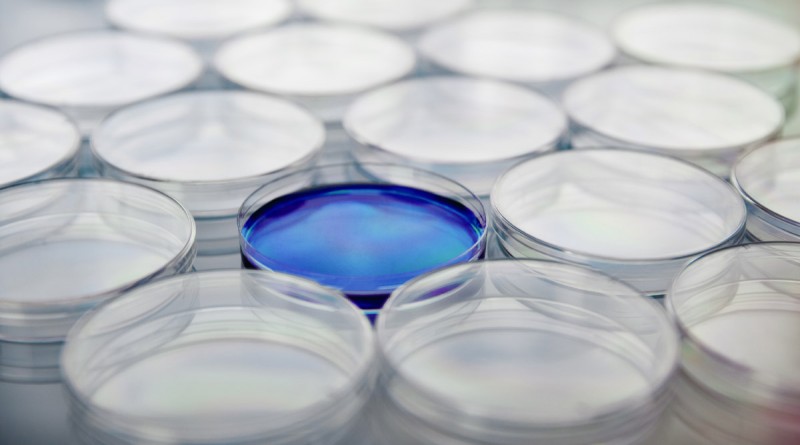

- Life Sciences
Quality control samples
Premium samples for quality control
Premium samples for quality control
Our quality control samples are designed to meet the highest laboratory standards, ensuring consistency and precision in your analyses. With a broad selection of standard-compliant samples, we provide the assurance you need to maintain peak laboratory performance. Rely on our expertise and dedication to quality to optimize your processes and uphold the highest standards in your lab. We help you manage every detail to guarantee the accuracy and reliability of your results.
Overview of our services
Microbiological Control: EN ISO 11133
Standard for the quality control of culture mediaChemical Analytics: EN ISO 17025
General requirements for the competence of testing and calibration laboratoriesEnvironmental Monitoring Samples: ISO 5667
Guidelines for the sampling of water, wastewater, and sedimentMedical Diagnostics: EN ISO 15189
Requirements for quality and competence in medical laboratoriesQuality Control for Proficiency Tests
Active Ingredients (secondary plant compounds): EN ISO 17025
Extracts, food/feed (dietary supplements, formulations), bodily fluids, medical devices and cosmetics
Our Experts:
The industries:
- Life Science
- Pharma
- Scientific community